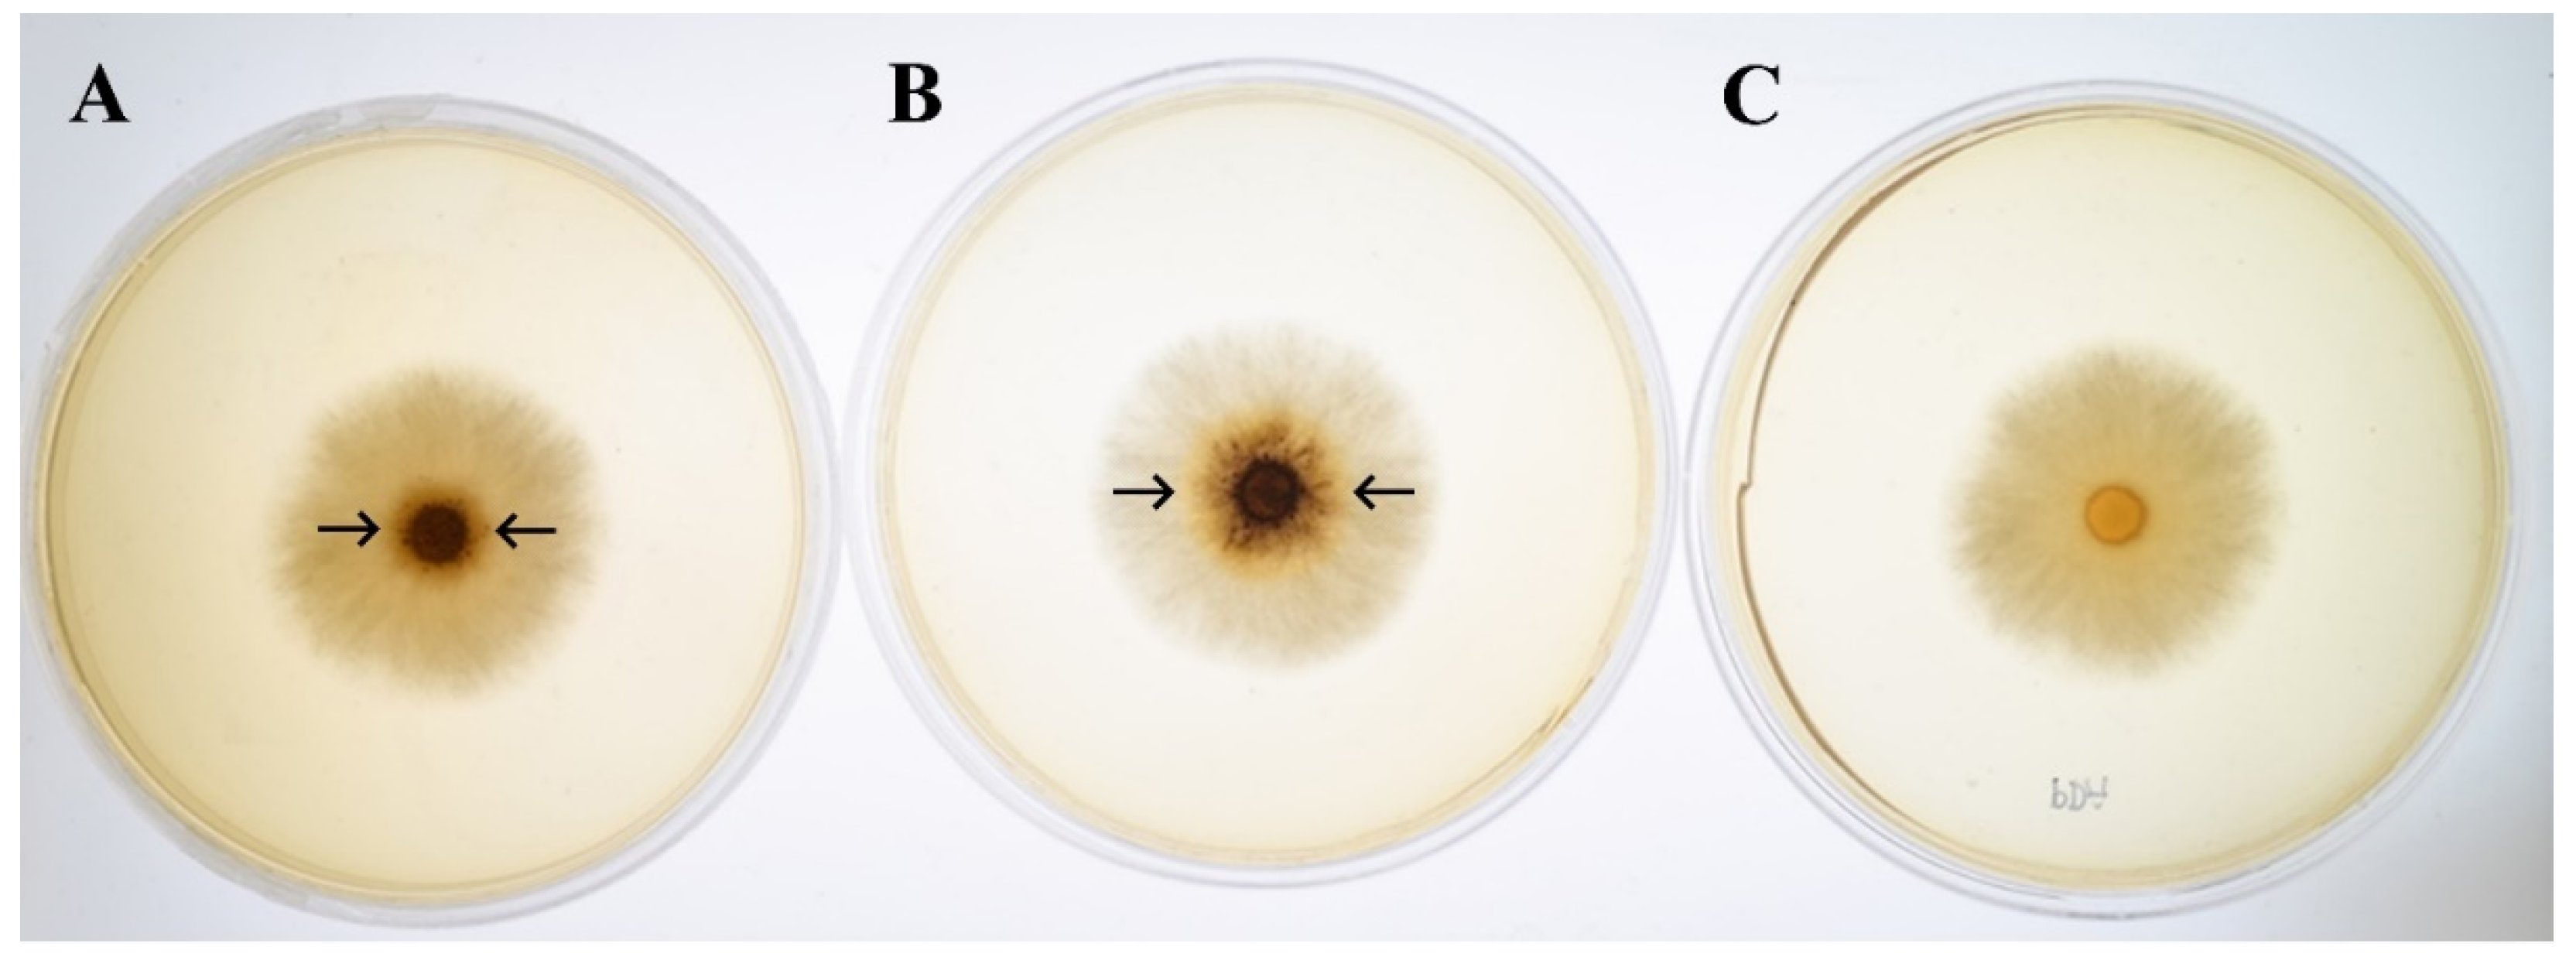
Microorganisms 08 00852 g004 Microorganisms 08 00852 g004

Light Regulation of Two New Manganese Peroxidase-Encoding Genes in Trametes polyzona KU-RNW027
Abstract
1. Introduction
2. Materials and Methods
2.1. Microorganism and Inoculum Preparation
2.2. Plate Assay of Light-Driven Ligninolytic Enzyme Activity
2.3. Effect of Light on Transcription Levels and Enzyme Production
2.4. Enzyme Stability under Different Wavelengths of Light
2.5. Enzyme Assay
2.6. Cloning of Ligninolytic Enzyme-Encoding Genes and Promoter Region
2.7. Cloning of cDNA of mnp1, mnp2, and lac1
2.8. Analysis of Gene Expression by Quantitative Real-Time PCR (qRT-PCR)
2.9. Statistical Analysis
3. Results and Discussion
3.1. Ligninolytic Enzyme-Encoding Genes of T. polyzona KU-RNW027
3.2. Promoter of Ligninolytic Enzyme-Encoding Genes
3.3. Regulation of Ligninolytic Enzyme Production and Gene Expression by Different Wavelengths of Light
3.3.1. Preliminary Plate Assay Study
3.3.2. Effect of Light on Transcription Levels and Enzyme Production
3.3.3. Effect of Light on Ligninolytic Enzyme Stability
4. Conclusions
Supplementary Materials
Author Contributions
Funding
Conflicts of Interest
References
- Purschwitz, J.; Muller, S.; Kastner, C.; Fischer, R. Seeing the rainbow: Light sensing in fungi. Curr. Opin. Microbiol. 2006, 9, 566–571. [Google Scholar] [CrossRef] [PubMed]
- Avalos, J.; Estrada, A.F. Regulation by light in Fusarium. Fungal Genet. Biol. 2018, 47, 930–938. [Google Scholar] [CrossRef] [PubMed]
- Schwerdtfeger, C.; Linden, H. VIVID is a favoprotein and serves as a fungal blue light photoreceptor for photoadaptation. EMBO J. 2003, 22, 4846–4855. [Google Scholar] [CrossRef] [PubMed]
- Idnurm, A.; Verma, S.; Corrochano, L.M. A glimpse into the basis of vision in the kingdom Mycota. Fungal Genet. Biol. 2010, 47, 881–892. [Google Scholar] [CrossRef]
- Verma, S.; Idnurm, A. The Uve1 endonuclease is regulated by the white collar complex to protect Cryptococcus neoformans from UV damage. PLoS Genet. 2013, 9, e1003769. [Google Scholar] [CrossRef] [PubMed]
- Miyake, T.; Mori, A.; Kii, T.; Okuno, T.; Usui, Y.; Sato, F.; Sammoto, H.; Watanabe, A.; Kariyama, M. Light effects on cell development and secondary metabolism in Monascus. J. Ind. Microbiol. Biotechnol. 2005, 32, 103–108. [Google Scholar] [CrossRef]
- Chen, D.; Gibson, E.S.; Kennedy, M.J. A light-triggered protein secretion system. J. Cell Biol. 2013, 201, 631–640. [Google Scholar] [CrossRef]
- Schumacher, J. How light affects the life of Botrytis. Fungal Genet. Biol. 2017, 106, 26–41. [Google Scholar] [CrossRef]
- Buck, J.W.; Dong, W.; Mueller, D.S. Effect of light exposure on in vitro germination and germ tube growth of eight species of rust fungi. Mycologia 2010, 102, 1134–1140. [Google Scholar] [CrossRef]
- Kamada, T.; Sano, H.; Nakazawa, T.; Nakahori, K. Regulation of fruiting body photomorphogenesis in Coprinopsis cinerea. Fungal Genet. Biol. 2010, 47, 917–921. [Google Scholar] [CrossRef]
- Yu, S.M.; Ramkumar, G.; Lee, Y.H. Light quality influences the virulence and physiological responses of Colletotrichum acutatum causing anthracnose in pepper plants. J. Appl. Microbiol. 2013, 115, 509–516. [Google Scholar] [CrossRef]
- Castrillo, M.; Luque, E.M.; Pardo-Medina, J.; Limon, M.C.; Corrochano, L.M.; Avalos, J. Transcriptional basis of enhanced photoinduction of carotenoid biosynthesis at low temperature in the fungus Neurospora crassa. Res. Microbiol. 2018, 169, 78–89. [Google Scholar] [CrossRef] [PubMed]
- Velmurugan, P.; Lee, Y.H.; Venil, C.K.; Lakshmanaperumalsamy, P.; Chae, J.; Oh, B. Effect of light on growth, intracellular and extracellular pigment production by five pigment-producing filamentous fungi in synthetic medium. J. Biosci. Bioeng. 2010, 109, 346–350. [Google Scholar] [CrossRef] [PubMed]
- Ramírez, D.A.; Muñoz, S.V.; Atehortua, L.; Michel, F.C., Jr. Effects of different wavelengths of light on lignin peroxidase production by the white-rot fungi Phanerochaete chrysosporium grown in submerged cultures. Bioresour. Technol. 2010, 101, 9213–9220. [Google Scholar] [CrossRef] [PubMed]
- Janusz, G.; Sulej, J.; Jaszek, M.; Osińska-Jaroszuk, M. Effect of different wavelengths of light on laccase, cellobiose dehydrogenase, and proteases produced by Cerrena unicolor, Pycnoporus sanguineus and Phlebia lindtneri. Acta. Biochem. Pol. 2016, 63, 223–228. [Google Scholar] [CrossRef]
- Zhang, G.; Liu, P.; Wei, W.; Wang, X.; Wei, D.; Wang, W. A light-switchable bidirectional expression system in filamentous fungus Trichoderma reesei. J. Biotechnol. 2016, 240, 85–93. [Google Scholar] [CrossRef]
- Piscitelli, A.; Giardina, P.; Lettera, V.; Pezzella, C.; Sannia, G.; Faraco, V. Induction and transcriptional regulation of laccases in fungi. Curr. Genom. 2011, 12, 104–112. [Google Scholar] [CrossRef]
- Janusz, G.; Kucharzyk, K.H.; Pawlik, A.; Staszczak, M.; Paszczynski, A.J. Fungal laccase, manganese peroxidase and lignin peroxidase: Gene expression and regulation. Enzyme Microb. Technol. 2013, 52, 1–12. [Google Scholar] [CrossRef]
- Yang, J.; Wang, G.; Ng, T.B.; Lin, J.; Ye, X. Laccase production and differential transcription of laccase genes in Cerrena sp. in response to metal ions, aromatic compounds and nutrients. Front. Microbiol. 2016, 6, 1558. [Google Scholar] [CrossRef]
- Srivastav, A.; Mehta, S.; Lindlof, A.; Bhargava, S. Over-represented promoter motifs in abiotic stress-induced DREB genes of rice and sorghum and their probable role in regulation of gene expression. Plant Signal Behav. 2010, 5, 775–784. [Google Scholar] [CrossRef]
- Lueangjaroenkit, P.; Teerapatsakul, C.; Chitradon, L. Morphological characteristic regulation of ligninolytic enzyme produced by Trametes polyzona. Mycobiology 2018, 46, 396–406. [Google Scholar] [CrossRef] [PubMed]
- Lueangjaroenkit, P.; Teerapatsakul, C.; Sakka, K.; Sakka, M.; Kimura, T.; Kunitake, E.; Chitradon, L. Two manganese peroxidases and a laccase of Trametes polyzona KU-RNW027 with novel properties for dye and pharmaceutical product degradation in redox mediator-free system. Mycobiology 2019, 47, 217–229. [Google Scholar] [CrossRef] [PubMed]
- Kondo, R.; Harazono, K.; Sakai, K. Bleaching of hardwood kraft pulp with manganese peroxidase secreted from Phanerochaete sordida YK 624. Appl. Environ. Microbiol. 1994, 60, 4359–4363. [Google Scholar] [CrossRef]
- Tamura, K.; Peterson, D.; Peterson, N.; Stecher, G.; Nei, M.; Kumar, S. MEGA5: Molecular evolutionary genetics analysis using maximum likelihood, evolutionary distance, and maximum parsimony. Mol. Biol. Evol. 2011, 28, 2731–2739. [Google Scholar] [CrossRef] [PubMed]
- Petersen, T.N.; Brunak, S.; von Heijne, G.; Nielsen, H. SignalP 4.0: Discriminating signal peptides from transmembrane regions. Nat. Methods 2011, 8, 785–786. [Google Scholar] [CrossRef]
- Shapiro, M.B.; Senapathy, P. RNA splice junctions of different classes of eukaryotes: Sequence statistics and functional implication in gene expression. Nucleic Acids Res. 1987, 11, 7155–7174. [Google Scholar] [CrossRef]
- Hofrichter, M.; Ullrich, R.; Pecyna, M.J.; Liers, C.; Lundell, T. New and classic families of secreted fungal heme peroxidases. Appl. Microbiol. Biotechnol. 2010, 87, 871–897. [Google Scholar] [CrossRef]
- Chen, W.; Zheng, L.; Jia, R.; Wang, N. Cloning and expression of a new manganese peroxidase from Irpex lacteus F17 and its application in decolorization of reactive black 5. Process Biochem. 2015, 50, 1748–1759. [Google Scholar] [CrossRef]
- Reinhart, J.; Pearson, W.R. The structure of two murine class-Mu glutathione transferase genes coordinately induced by butylated hydroxyanisole. Arch. Biochem. Biophys. 1993, 303, 383–393. [Google Scholar] [CrossRef]
- Nakade, K.; Nakagawa, Y.; Yano, A.; Konno, N.; Sato, T.; Sakamoto, Y. Effective induction of pblac1 laccase by copper ion in Polyporus brumalis ibrc05015. Fungal Biol. 2013, 117, 52–61. [Google Scholar] [CrossRef]
- Yang, Y.; Wei, F.; Zhuo, R.; Fan, F.; Liu, H.; Zhang, C.; Ma, L.; Jiang, M.; Zhang, X. Enhancing the laccase production and laccase gene expression in the white-rot fungus Trametes velutina 5930 with great potential for biotechnological applications by different Metal ions and aromatic compounds. PLoS ONE 2013, 8, e79307. [Google Scholar] [CrossRef]
- Takashima, S.; Iikura, H.; Nakamura, A.; Masaki, H.; Uozumi, T. Analysis of Crel binding sites in the Trichoderma reesei cbhl upstream region. FEMS Microbiol. Lett. 1996, 145, 361–366. [Google Scholar] [CrossRef]
- Bonner, J.J.; Ballou, C.; Fackenthal, D.L. Interactions between DNA-Bound Trimers of the Yeast Heat Shock Factor. Mol. Cell Biol. 1994, 14, 501–508. [Google Scholar] [CrossRef][Green Version]
- Bae, S.; Han, H.W.; Moon, J. Functional analysis of the molecular interactions of TATA box-containing genes and essential genes. PLoS ONE 2015, 10, e0120848. [Google Scholar] [CrossRef]
- Dai, Z.; An, K.; Edward, G.E.; An, G. Functional role of CAAT box element of the nopaline synthase (nos) promoter. J. Plant Biol. 1999, 42, 181–185. [Google Scholar] [CrossRef]
- Pawlik, A.; Jaszek, M.; Sulej, J.; Janusz, G. Light-regulation synthesis of extra- and intracellular enzymes related to wood degradation by the white rot fungus Cerrena unicolor during solid-state fermentation on ash sawdust-based medium. Acta Biochim. Pol. 2019, 66, 419–425. [Google Scholar]
- Pawlik, A.; Mazur, A.; Wielbo, J.; Koper, P.; Zebracki, K.; Kubik-Komar, A.; Janusz, G. RNA sequencing reveals differential gene expression of Cerrena unicolor in response to variable lighting conditions. Int. J. Mol. Sci. 2019, 20, 290. [Google Scholar] [CrossRef]
- Schierling, B.; Noël, A.; Wende, W.; Hien, L.T.; Volkov, E.; Kubareva, E.; Oretskaya, T.; Kokkinidis, M.; Römpp, A.; Spengler, B.; et al. Controlling the enzymatic activity of a restriction enzyme by light. Proc. Natl. Acad. Sci. USA 2010, 107, 1361–1366. [Google Scholar] [CrossRef]

). Conserved heme pocket residues are indicated by solid rectangles (
). Mn2+ binding sites are indicated by hollow triangles (
). Ca2+ binding sites are indicated by circles (
). Oxidation sites of the substrate are indicated by hollow rectangles (
). TP: Trametes polyzona; LG: Lenzites gibbosa; DS: Dichomitus squalens; PB: Polyporus brumalis; TV: Trametes versicolor. A putative signal peptide was analyzed using SignalP 4.0 [25].
). Conserved heme pocket residues are indicated by solid rectangles (
). Mn2+ binding sites are indicated by hollow triangles (
). Ca2+ binding sites are indicated by circles (
). Oxidation sites of the substrate are indicated by hollow rectangles (
). TP: Trametes polyzona; LG: Lenzites gibbosa; DS: Dichomitus squalens; PB: Polyporus brumalis; TV: Trametes versicolor. A putative signal peptide was analyzed using SignalP 4.0 [25].

) and laccase (
) activities in the culture supernatant were determined after 7 days of cultivation under different wavelengths of light. Transcriptional levels of the mnp1 (
), mnp2 (
), and lac1 (
) genes were determined using mycelia harvested from the cultures after 7 days of cultivation under different wavelengths of light. Transcription levels of mnp1, mnp2, and lac1 are shown as induction fold values relative to those observed under the dark condition. Error bars represent standard deviation (n = 3). a, b, and c represent significant enzyme production and gene expression compared to the control (p < 0.05).
) and laccase (
) activities in the culture supernatant were determined after 7 days of cultivation under different wavelengths of light. Transcriptional levels of the mnp1 (
), mnp2 (
), and lac1 (
) genes were determined using mycelia harvested from the cultures after 7 days of cultivation under different wavelengths of light. Transcription levels of mnp1, mnp2, and lac1 are shown as induction fold values relative to those observed under the dark condition. Error bars represent standard deviation (n = 3). a, b, and c represent significant enzyme production and gene expression compared to the control (p < 0.05).
), tungsten light (
), and blue light (
).
), tungsten light (
), and blue light (
).
© 2020 by the authors. Licensee MDPI, Basel, Switzerland. This article is an open access article distributed under the terms and conditions of the Creative Commons Attribution (CC BY) license (http://creativecommons.org/licenses/by/4.0/).
Share and Cite
Lueangjaroenkit, P.; Kunitake, E.; Sakka, M.; Kimura, T.; Teerapatsakul, C.; Sakka, K.; Chitradon, L. Light Regulation of Two New Manganese Peroxidase-Encoding Genes in Trametes polyzona KU-RNW027. Microorganisms 2020, 8, 852. https://doi.org/10.3390/microorganisms8060852
Lueangjaroenkit P, Kunitake E, Sakka M, Kimura T, Teerapatsakul C, Sakka K, Chitradon L. Light Regulation of Two New Manganese Peroxidase-Encoding Genes in Trametes polyzona KU-RNW027. Microorganisms. 2020; 8(6):852. https://doi.org/10.3390/microorganisms8060852
Chicago/Turabian StyleLueangjaroenkit, Piyangkun, Emi Kunitake, Makiko Sakka, Tetsuya Kimura, Churapa Teerapatsakul, Kazuo Sakka, and Lerluck Chitradon. 2020. "Light Regulation of Two New Manganese Peroxidase-Encoding Genes in Trametes polyzona KU-RNW027" Microorganisms 8, no. 6: 852. https://doi.org/10.3390/microorganisms8060852
APA StyleLueangjaroenkit, P., Kunitake, E., Sakka, M., Kimura, T., Teerapatsakul, C., Sakka, K., & Chitradon, L. (2020). Light Regulation of Two New Manganese Peroxidase-Encoding Genes in Trametes polyzona KU-RNW027. Microorganisms, 8(6), 852. https://doi.org/10.3390/microorganisms8060852

